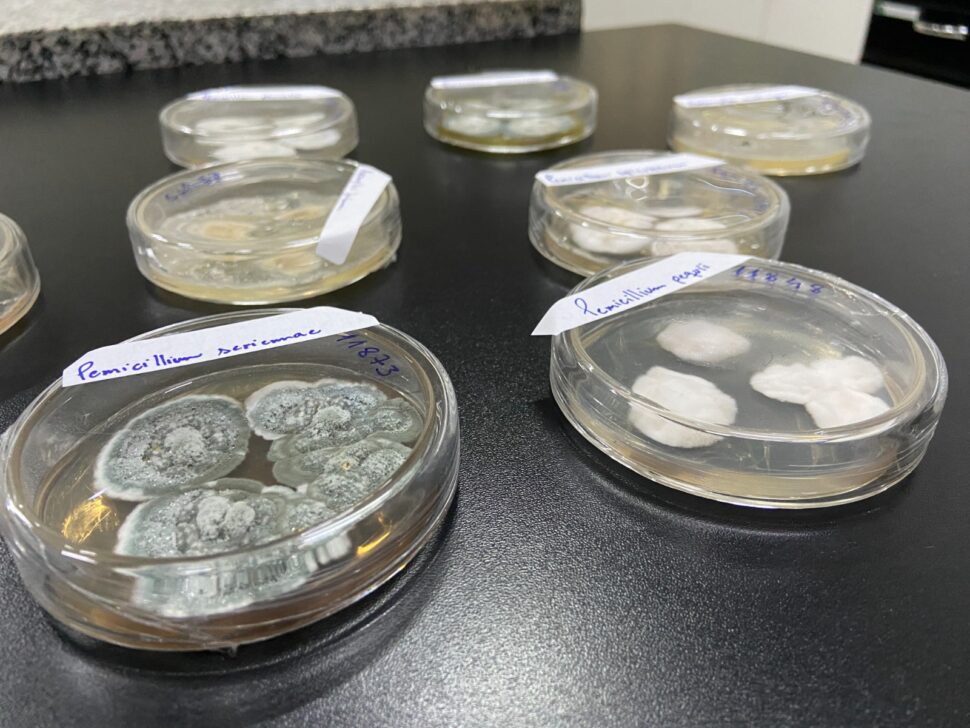

URMICRO conquista certificação ISO 9001:2015 e consolida padrão internacional de qualidade na UFLA
fevereiro 13, 2026

Por Simone Paiva – Analista de Comunicação da FUNDECC – 13 de fevereiro de 2026.
Uma das coleções de microrganismos da Universidade Federal de Lavras (UFLA), a Unidade de Recursos Microbiológicos URMICRO/UFLA, conquistou a certificação ISO 9001:2015, norma internacional que atesta sistemas de gestão da qualidade. A URMICRO/UFLA sediada no Centro de Biodiversidade e Patrimônio Genético (CEBIOMinas/UFLA), um conjunto de laboratórios multiusuários, passa a integrar o grupo restrito de laboratórios brasileiros com esse reconhecimento e é a única certificada em Minas Gerais.
A auditoria foi conduzida pela DNV (Det Norske Veritas), certificadora internacional de origem norueguesa, que avaliou protocolos técnicos, rastreabilidade de insumos, controle de equipamentos e organização documental.
Coordenado pelo professor e pró-reitor de Pesquisa e Inovação da UFLA, doutor em Ciência dos Alimentos, Luís Roberto Batista, o laboratório alcança a certificação após 8 anos de estruturação e adequações.

“Não é apenas um certificado. A ISO 9001:2015 comprova que nossos processos seguem padrões internacionais. Cada procedimento é documentado, cada reagente tem origem comprovada e cada resultado pode ser auditado. Isso fortalece a credibilidade científica”, afirma.
A ISO 9001:2015 certifica o sistema que sustenta a produção científica. Na URMICRO, isso significa controle rigoroso desde a entrada de insumos até a preservação e disponibilização dos microrganismos.
“Nós desenvolvemos e ampliamos protocolos, intensificamos o monitoramento dos equipamentos e estruturamos a rastreabilidade completa dos materiais. A qualidade deixa de ser apenas técnica e passa a ser institucional”, explica Batista.
Criada em 2010, no Departamento de Ciência dos Alimentos (DCA) a coleção já operava com boas práticas de laboratório. Em 2015, tornou-se Fiel Depositária junto ao Ministério do Meio Ambiente e passou a integrar a Federação Mundial de Coleções de Cultura. A decisão de buscar a certificação amadureceu após experiências internacionais e da necessidade de alinhar o laboratório aos padrões globais.
O processo foi viabilizado com financiamento da Financiadora de Estudos e Projetos (FINEP) e da Fundação de Amparo à Pesquisa do Estado de Minas Gerais (FAPEMIG). A Fundação de Desenvolvimento Científico e Cultural (FUNDECC), fundação de apoio à UFLA, atuou na gestão administrativa dos recursos, aquisição de insumos e organização documental exigida pela norma.
“A certificação exige rastreabilidade inclusive nas compras. Sem gestão adequada, ela não acontece. O apoio da FUNDECC foi fundamental nesse processo”, destaca o professor.
Hoje, o URMICRO preserva cerca de 1.500 isolados de fungos filamentos e leveduras e possui capacidade para armazenar até 30 mil amostras a menos 80 graus Celsius. A coleção sustenta pesquisas em biodiversidade microbiana, biotecnologia, controle biológico e microbiologia de alimentos, além de ter contribuído para estudos que apoiaram a regulamentação do Queijo Minas Artesanal Casca Florida Natural que é produzido com leite cru e para o reconhecimento dos “Os Modos de Fazer o Queijo Minas Artesanal” fossem reconhecidos como Patrimônio Cultural Imaterial da Humanidade pela UNESCO em dezembro de 2024. A URMICRO conta também com um Banco de Queijos Artesanais, preservados a -80ºC.
“A coleção não é um depósito de microrganismos. Ela contribui para a preservação da história, cultura e patrimônio genético brasileiro, para ações governamentais voltadas para regulamentação de alimentos, para o conhecimento da biodiversidade brasileira, para a formação de recursos humanos qualificados e sustenta pesquisas que impactam diretamente a sociedade”, reforça Batista.
Enquanto auditorias confirmam padrões e relatórios organizam processos, os ultrafreezers continuam funcionando dia e noite. Ali estão preservados os queijos artesanais e microrganismos que podem responder a desafios científicos futuros.
Mais do que um reconhecimento, a certificação consolida um compromisso permanente com qualidade, responsabilidade e preservação para as próximas gerações.
Confira alguns registros fotográficos dessa reportagem: